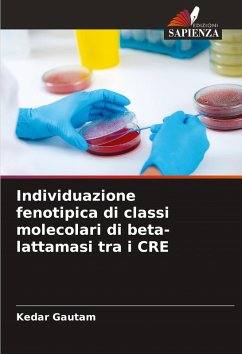

Phenotypic Detection of Molecular Classes of beta-lactamases among CRE
Versandkostenfrei!
Versandfertig in 6-10 Tagen
41,99 €
inkl. MwSt.

PAYBACK Punkte
21 °P sammeln!
This book is a work conducted in Kanti Children Hospital, Kathmandu to determine the burden of carbapenem resistant isolates of Enterobacteriaceae producing different types of beta-lactamases.It has been observed that, all the classes of carbapenemases have emerged among the Enterobacteriaceae. Since, the profound variation is found in beta-lactamases of CRE, to reduce the risk of severe calamity effective detection procedures are mandatory in all the clinical laboratories.